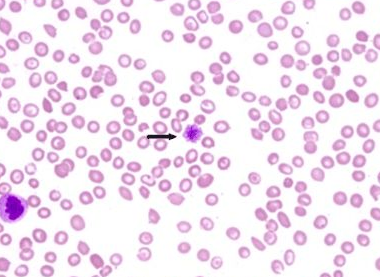

如何预防药源性疾病
药源性疾病的防治与药品不良反应的防治息息相关,前者更侧重于管理方面的加强,重视预防药源性疾病。原则上若怀疑出现的病症是由药物所致,首先应停止应用所有药物,终止致病药物继续损害机体,并采取及时的抢救措施。
1.加强认识,慎重用药

加强对药源性疾病的认识,普及药源性疾病的知识,使医药卫生工作者与公众重视药源性疾病知识及其防治,重视药源性疾病的危害,慎重选用药物。
2.加强管理
认真贯彻《药品管理法》,加强药品的监督管理,是预防药源性疾病的法律措施。对药品生产、经营企业和医院制剂实行许可证制度;严格药品标准审定,颁布药品品种的审批权限;对麻醉药品、精神药品、放射性药品、毒性药品由国家实行特殊管理;加强中药材管理;严格进口药品和出口药品的审批原则;依法惩处制售假劣药的单位和个人;凡违反《药品管理法》者,必须承担法律责任;依法打击不科学、不真实的虚假广告等。
3.加强临床药学服务
药学与临床工作相结合是预防药源性疾病的重要措施。医师与药师应面向临床患者,了解药物的药效学与药动学规律、不良反应的性质和程度,对其安全性、有效性做出评价,以决定患者是否应用;以患者为对象,综合运用药理学和药剂学知识做好防范措施,确保用药安全;对作用强烈,治疗指数低的药物进行血药浓度监测,为调整给药量提供科学依据。
4.坚持合理用药
正确、有效、安全的用药是预防药源性疾病的有效措施。①要明确诊断,依据病情和药物适应证,正确选用药物。②根据治疗对象的个体差异、生理特点及药学知识,研究给药方案是否合理,有无药物相互作用及配伍禁忌。③监督患者的用药行为,观察药物疗效和不良反应,及时调整治疗方案和处理不良反应。
④要慎重使用新药。⑤根据病情缓急、用药目的及药物性质,确定给药剂量、给药时间、给药方法及疗程;老人服药,儿童服药都应在帮助患者用完药后离开。⑥尽量减少联合用药,使用复方制剂一定要了解所含药物成分,避免不良的药物相互作用。⑦药师、护士发放药物应做到“三查七对”,避免发错药物。

5.加强医药科普教育
运用大众传播媒体及一切可能的场合,提高全民族的卫生防病知识是预防药源性疾病的基本措施。崇尚科学,有病去医院看医生;自行购药要接受医生的指导,不轻信广告宣传,不迷信“祖传名医”等;用药要规范,要尽量做到按时遵医嘱用药,漏服要补上;另外,医药护技人员高尚的医德、耐心的解释会增强治疗的信心,防止患者乱投医,滥用药物。
6.加强药品不良反应监测报告制度
向国家药品监督管理机构报告药物引起的任何严重或意外变化是预防药源性疾病再发生的必要措施。
药源性疾病的预防措施
(一)认真贯彻《药品管理法》
《药品管理法》是法律对预防药源性疾病的保障。如对麻醉药品、精神药品、放射性药品、毒性药品,则是由国家实行特殊管理。同时加强中药材管理,严格进口和出口药品的审批原则,实行许可证制度。对药品的生产、经营企业和医院制剂,严格按药品标准审定,颁布药品品种的审批权限。对于制造、销售假药、劣药的单位和个人进行严厉打击。对于不科学、不真实的虚假广告必须依法严厉打击。
(二)完善药品不良反应监测报告制度
政府和医疗机构应要加强药物安全信息工作,有效地指导临床安全、合理用药,减少和预防药源性疾病的发生。
1.国家各级药政管理部门要加强不良反应的技术咨询,定期发布通报、警告药物不良反应的新情况和防范措施?
2.医疗机构对药源性疾病的知识应该加大普及力度,对药品在使用过程中可能发生药源性疾病进行评估,建立不良反应报告卡,提高广大医务工作者对药源性疾病的重视程度,掌握对药源性疾病的诊断和防治,保障用药安全。
(三)提高临床医师的安全用药水平

1.临床用药前,应该充分了解患者的药物反应史、过敏史、遗传缺陷和家族史等,做到对症用药,切忌随意用药;选择药物要权衡利弊,尽量做到个体化。注意药物的用法与用量。
2.尽量避免不必要的联合用药,可减少ADR的发生
3.针对特殊人群的用药,注意选择适合的药物,预防药源性疾病的发生。
(1)老年人不仅应提醒患者可能出现的ADR,还应注意老年人的器官功能减退,药物在体内的代谢和排泄减弱,而致解毒能力下降,易发生ADR。
(2)小儿尤其是新生儿和婴幼儿,由于其各系统器官功能未发育完全,肝脏对药物的解毒作用及肾脏对药物的排泄功能低下,易发生ADR,所以在用药时,应按体重或体表面积计算其剂量,并加强观察。
(3)孕妇和哺乳期妇女用药应特别慎重,尤其是妊娠初期3个月内应尽量避免使用药物,用药不当有可能致胎儿畸形。哺乳期用药应注意对婴儿的影响。
4.对于肝病和肾病患者,由于药物在体内的消除速率降低,半衰期延长,血药浓度增高,药物不良反应率将增加。除了注意选用对肝肾功能无不良影响的药物外,用药剂量也应减少。
5.使用对器官功能有损害的药物时,须按规定检查器官功能。如利福平、异烟肼使用前应检查肝功能,氨基糖苷类抗生素使用前检查听力、肾功能,氯霉素使用前检查血象。
6.用药过程中,发现ADR的早期症状或迟发反应,应及时停药和处理。
7.对于中草药、中成药及其制剂应该合理使用,部分中药含有毒性成分时,更应严格遵守用药剂量,防治药物中毒;
(四)加强临床药师的作用
建立健全临床药师制度,发挥临床药师的作用,是减少ADR和药源性疾病的重要环节。
1.临床药师要深入临床第一线,加强药物安全信息的收集和交流,提供正确的药学信息,指导或协助医生制定合理的给药方案,实施全面的药学监护,预防_药源性疾病的发生。
2.临床药学和临床药理学都是在众多药害事件和药源性疾病的教训下,为安全、合理、高效用药而新发展的学科。临床药师应积极开展保障安全用药的一些检测项目,如血药浓度监测、药物不良反应监测、药物代谢酶和药物作用靶点的基因筛查等,对提高医疗质量,减少药源性疾病的发生是非常必要的。
3.临床药师应利用自己掌握的专业知识,开展患者用药咨询和用药教育,宣传、普及合理用药的基本常识,避免药源性疾病的发生。